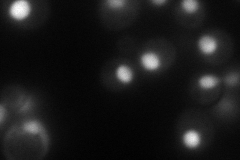
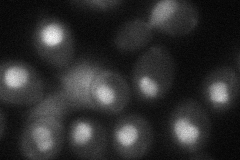

View description
Essential protein involved in ribosome biogenesis; putative ATP-dependent RNA helicase of the DEAD-box protein family
Localization:
Intensity:
Fold change:
Significance:
-
C’ GFP library in SD

below threshold17.88 -
N' NOP1pr-GFP in SD
nucleus108.624 -
N' TEF2pr-mCherry in SD

nucleus104.167 -
N' NATIVEpr-GFP in SD

nucleus35.8999 -
N' TEF2pr-VC and Cyto-VN in SD
nucleus50.7066 -
C’ GFP library in SD+DTT

cytosol17.240.96No -
C’ GFP library in SD+H2O2

cytosol18.161.01No -
C’ GFP library in Starvation Media

cytosol16.330.91No -
C’ GFP library on the background of Pup2-DaMP

below threshold -
C’ GFP library on the background of CCT mutant

below threshold20.34721.13727No
